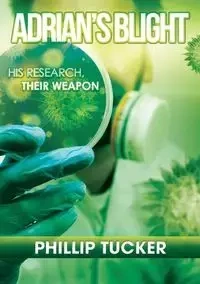

Adrian's Blight - Phillip Tucker J
Adrian's Blight - Phillip Tucker J
AutorzyPhillip Tucker J
EAN: 9780994321756
Marka
Symbol
198FDG03527KS
Rok wydania
2015
Elementy
230
Oprawa
Miekka
Format
14.8x21.0cm
Język
angielski

Bez ryzyka
14 dni na łatwy zwrot

Szeroki asortyment
ponad milion pozycji

Niskie ceny i rabaty
nawet do 50% każdego dnia
Niepotwierdzona zakupem
Ocena: /5
Marka
Symbol
198FDG03527KS
Kod producenta
9780994321756
Rok wydania
2015
Elementy
230
Oprawa
Miekka
Format
14.8x21.0cm
Język
angielski
Autorzy
Phillip Tucker J

His research, their weapon
A young man dreams of honouring his father's memory, by changing the World. Having been invited to attend a prestigious think tank University in America, Adrian thinks his wish has come true. While carrying out his revolutionary experiments on DNA weed eradication, Adrian comes face to face with the illusionary truth.
What is his research really being used for? And has he been deceived like his father before him? With the worlds most dangerous men hunting him, Adrian must decide what to do about his research and his supposed allies.
EAN: 9780994321756
EAN: 9780994321756
Niepotwierdzona zakupem
Ocena: /5
Zapytaj o produkt
Niepotwierdzona zakupem
Ocena: /5
Napisz swoją opinię